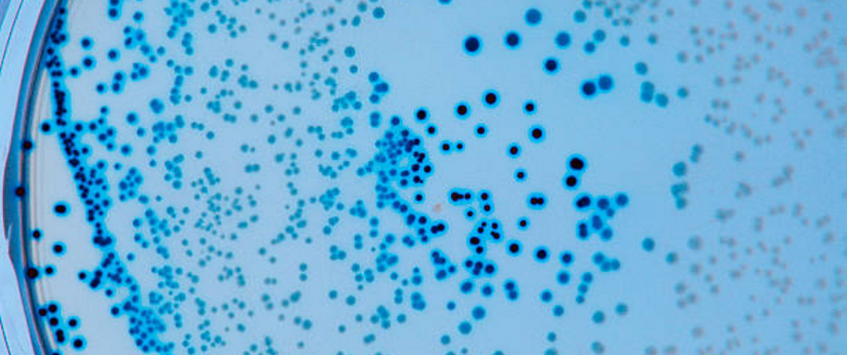

Praktyka
Kliniczna
Kliniczna
Anestezjologia
Behawioryzm
Chirurgia
Choroby wewnętrzne
Choroby zakaźne
Dermatologia
Diagnostyka laboratoryjna
Diagnostyka obrazowa
Endokrynologia
Farmakologia i toksykologia
Gastroenterologia
Geriatria
Hematologia
Kardiologia
Laryngologia
Nefrologia i Urologia
Neurologia
Okulistyka
Onkologia
Ortopedia
Parazytologia
Rehabilitacja
Rozród
Stany nagłe
Stomatologia
Żywienie